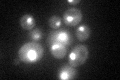
YNL308C
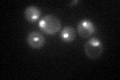
YNL308C
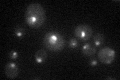
YNL308C

View description
Essential nucleolar protein required for 40S ribosome biogenesis; physically and functionally interacts with Krr1p
Localization:
Intensity:
Fold change:
Significance:
-
C’ GFP library in SD
nucleus, cytosol63.16 -
N' NOP1pr-GFP in SD

nucleolus117.605 -
N' TEF2pr-mCherry in SD

nucleus,nucleolus196.962 -
N' NATIVEpr-GFP in SD

nucleus,nucleolus79.6158 -
N' TEF2pr-VC and Cyto-VN in SD

nucleus,nucleolus57.4805 -
C’ GFP library in SD+DTT

nucleus, cytosol52.770.83No -
C’ GFP library in SD+H2O2
nucleus, cytosol68.631.08No -
C’ GFP library in Starvation Media
punctateN/AN/AYes -
C’ GFP library on the background of Pup2-DaMP

nucleus, cytosol -
C’ GFP library on the background of CCT mutant

nucleus, cytosol67.81041.07354No
